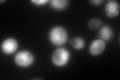
YPR056W

View description
Subunit of TFIIH complex, involved in transcription initiation, similar to 34 kDa subunit of human TFIIH; interacts with Ssl1p
Localization:
Intensity:
Fold change:
Significance:
-
C’ GFP library in SD

cytosol368.92 -
N' NOP1pr-GFP in SD

nucleus35.5775 -
N' TEF2pr-mCherry in SD

nucleus9.34903 -
N' NATIVEpr-GFP in SD

nucleus22.4583 -
N' TEF2pr-VC and Cyto-VN in SD

below threshold24.5997 -
C’ GFP library in SD+DTT

cytosol439.471.19No -
C’ GFP library in SD+H2O2

cytosol338.660.91No -
C’ GFP library in Starvation Media
nucleusN/AN/AYes -
C’ GFP library on the background of Pup2-DaMP

cytosol -
C’ GFP library on the background of CCT mutant

cytosol348.8820.945679No
